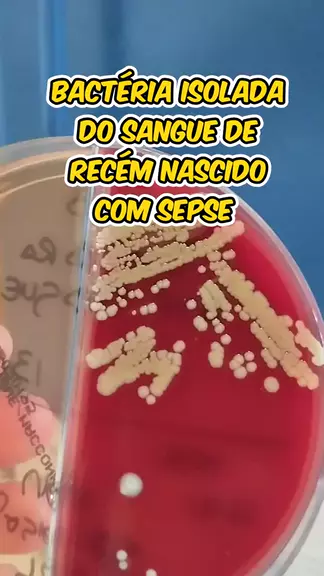

Ikuti
36
1
14
Biomédica microbiologista - hospital
bactéria staphylococcus aureus isolada do sangue de recém nascido com sepse #medicina #gestante #prenatal #ProvaDoAnjoKwaiLite #daumavoltinha
Lebih banyak
Komentar
Batal
Kirim